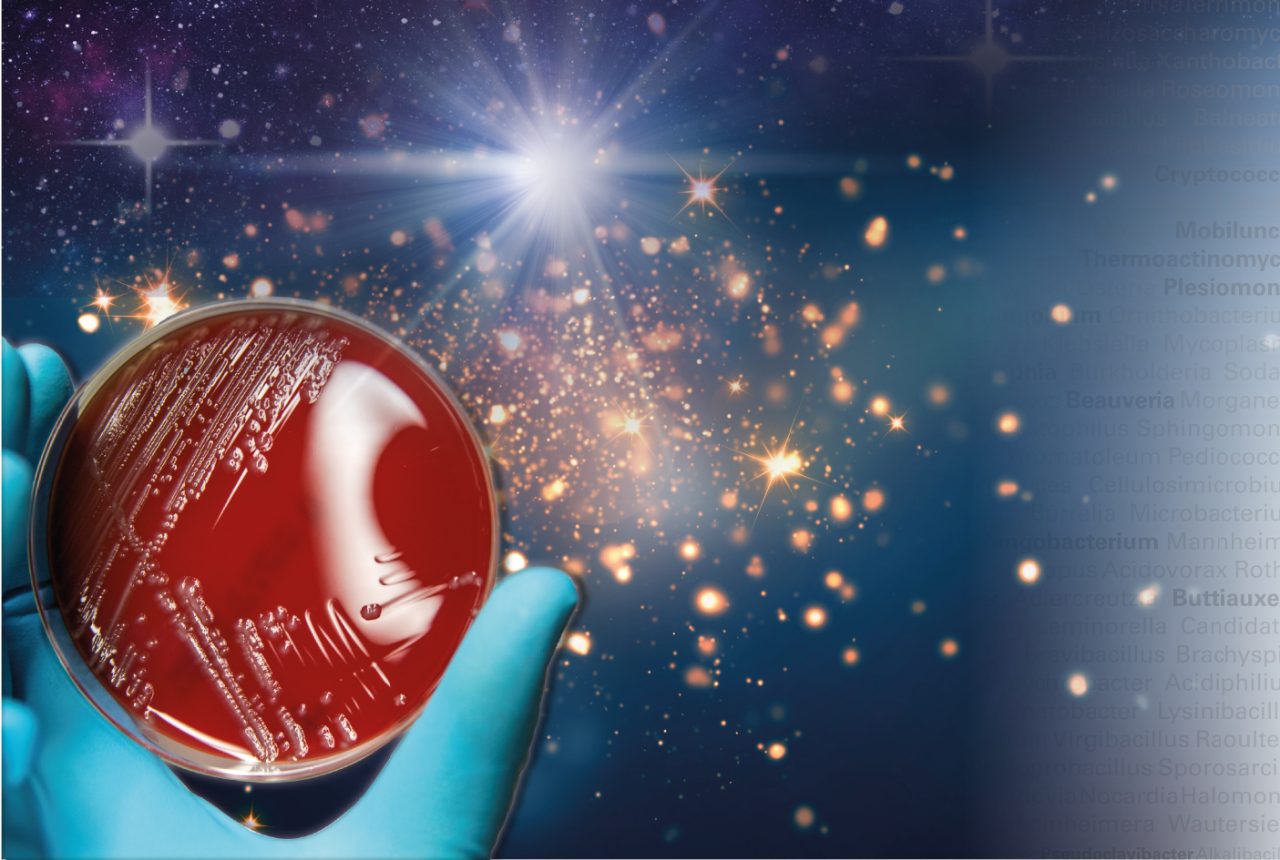
MBT sirius-web

Microbiological Research
Microbiological Research
Understanding the epidemiology of various microorganisms is a key focus of microbiological research laboratories across the globe. Accurate and rapid microbial identification is vital for tracking the pathogenicity, virulence and antimicrobial resistance of strains and subspecies in the population, for clinical researchers as well as those in the food, veterinary, environmental and pharmaceutical industries.
State-of-the-art microorganism identification
Advanced technology, such as Matrix-Assisted Laser Desorption/Ionization Time-Of-Flight Mass Spectrometry (MALDI-TOF MS), is capable of identifying microorganisms to the species level, and classifying them based on their molecular fingerprint. Traditional sequence-based technologies cannot tackle the diversity of microorganisms that most microbiological research programs strive to examine.
MALDI-TOF MS provides microbial identification by matching the unique proteomic fingerprint of an unknown to an extensive library of reference spectra.
Custom libraries
In order for microbiological research libraries to benefit the community as a whole, they must be continuously updated to encompass as broad a range of species as possible. Although Bruker’s MALDI Biotyper® covers more than 4,700 species, thousands more are yet to be discovered. Microbiological researchers can optimize the microorganism classification process by creating, modifying and organizing reference spectrum data with an open library concept.
Sophisticated subtyping
Some genera are more challenging to differentiate than others, despite the power of MALDI-TOF MS. Subtyping, in addition to identification, facilitates the research of such organisms by providing unparalleled discriminatory power. By distinguishing between different strains or subspecies, researchers can track infectious disease outbreaks, monitor food pathogen outbreaks, and study sources of contamination in manufacturing processes, such as pharmaceutical production.